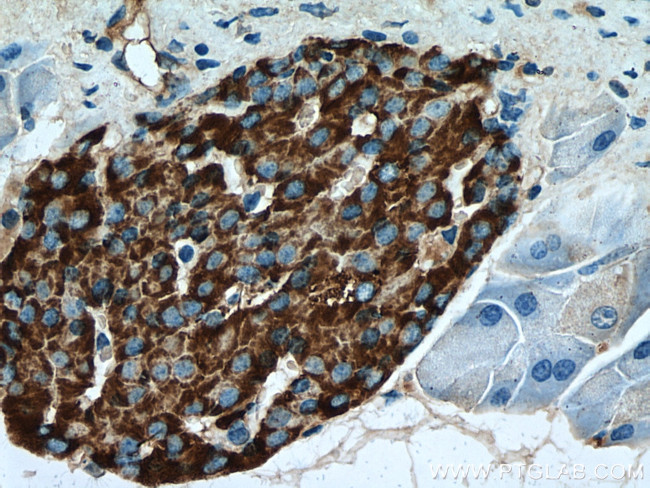
Secretogranin III Antibody in Immunohistochemistry (Paraffin) (IHC (P))

Search
Proteintech
Secretogranin III Polyclonal Antibody
{{$productOrderCtrl.translations['antibody.pdp.commerceCard.promotion.promotions']}}
{{$productOrderCtrl.translations['antibody.pdp.commerceCard.promotion.viewpromo']}}
{{$productOrderCtrl.translations['antibody.pdp.commerceCard.promotion.promocode']}}: {{promo.promoCode}} {{promo.promoTitle}} {{promo.promoDescription}}. {{$productOrderCtrl.translations['antibody.pdp.commerceCard.promotion.learnmore']}}
产品信息
10954-1-AP
种属反应
已发表种属
宿主/亚型
分类
类型
抗原
偶联物
形式
浓度
规格
纯化类型
保存液
内含物
保存条件
运输条件
产品详细信息
Immunogen sequence: MGFLGTGTW ILVLVLPIQA FPKPGGSQDK SLHNRELSAE RPLNEQIAEA EEDKIKKTYP PENKPGQSNY SFVDNLNLLK AITEKEKIEK ERQSIRSSPL DNKLNVEDVD STKNRKLIDD YDSTKSGLDH KFQDDPDGLH QLDGTPLTAE DIVHKIAARI YEENDRAAFD KIVSKLLNLG LITESQAHTL EDEVAEVLQK LISKEANNYE EDPNKPTSWT ENQAGKIPEK VTPMAAIQDG LAKGENDETV SNTLTLTNGL ERRTKTYSED NFEELQYFPN FYALLKSIDS EKEAKEKETL ITIMKTLIDF VKMMVKYGTI SPEEGVSYLE NLDEMIALQT KNKLEKNATD NISKLFPAPS EKSHEETDST KEEAAKMEKE YGSLKDSTKD DNSNPGGKTD EPKGKTEAYL EAIRKNIEWL KKHDKKGNKE DYDLSKMRDF INKQADAYVE KGILDKEEAE AIKRIYSSL (1-468 aa encoded by BC014539 )
靶标信息
The protein encoded by this gene is a member of the chromogranin/secretogranin family of neuroendocrine secretory proteins. Granins may serve as precursors for biologically active peptides. Some granins have been shown to function as helper proteins in sorting and proteolytic processing of prohormones; however, the function of this protein is unknown. Two transcript variants encoding different isoforms have been found for this gene.
仅用于科研。不用于诊断过程。未经明确授权不得转售。
生物信息学
蛋白别名: Secretogranin III; Secretogranin-3; SGIII; unnamed protein product
基因别名: 1B1075; AI385542; Chgd; SCG3; SGIII; UNQ2502/PRO5990
UniProt ID: (Human) Q8WXD2, (Mouse) P47867
Entrez Gene ID: (Human) 29106, (Mouse) 20255